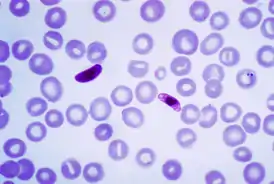

Plasmodium falciparum
Plasmodium falciparum — вид простейших паразитов из рода Plasmodium, вызывающий малярию у людей. Передаётся самками комаров из рода Anopheles. Малярия, которая вызывается этим видом, иногда называется молниеносной или тропической[1] и является самой опасной формой болезни[2], с самым высоким уровнем смертности. По состоянию на 2006 год, в мире насчитывалось 247 миллионов заражений малярией (98 % в Африке, 70 % среди детей моложе 6 лет)[3]. Практически все случаи смерти от малярии происходят при заражении Plasmodium falciparum[3].
| Plasmodium falciparum | ||||||
|---|---|---|---|---|---|---|
![]() Мазок крови с Plasmodium falciparum | ||||||
| Научная классификация | ||||||
|
Домен: Клада: Надтип: Тип: Класс: Aconoidasida Отряд: Семейство: Plasmodiidae Род: Вид: Plasmodium falciparum |
||||||
| Международное научное название | ||||||
| Plasmodium falciparum William H. Welch, 1897 | ||||||
| ||||||
Жизненный цикл
Заражение человека начинается с укуса комара-переносчика из рода Anopheles. Спорозоиты из слюнных желёз комара проникают в кровь человека и с током крови добираются до печени, где внедряются в её гепатоциты в течение 30 минут после укуса. В течение следующих двух недель в гепатоцитах происходит деление, образовавшееся потомство носит название мерозоиты. Десятки тысяч мерозоитов проникают из клеток печени в кровь, внедряясь в эритроциты, где проходит следующий этап размножения[4]. Клинические симптомы малярии, такие как высокая температура и озноб, приурочены к прорыву инфицированных эритроцитов. Высвобожденные мерозоиты находят себе новые эритроциты, цикл повторяется несколько раз, приводя к лавинообразному увеличению численности мерозоитов. Некоторые из мерозоитов развиваются в незрелые половые клетки — гаметоциты. Эти гаметоциты, находящиеся в крови больного малярией, попадают в организм других комаров при укусе ими такого человека. Внутри комара мужские гаметоциты производят восемь жгутиковых микрогамет, оплодотворяющих женские макрогаметы. Получившаяся оокинета пробуривает кишечную стенку и прикрепляется к её внешней стороне в виде ооцисты. Вскоре ооциста прорывается, высвобождая сотни спорозоитов, проникающих в полость тела комара и далее в слюнные железы. После этого насекомое становится опасным.
Примечания
- PMID 22110393
- Perlmann, P; Troye-Blomberg, M. Malaria blood-stage infection and its control by the immune system (англ.) // Folia biologica : journal. — 2000. — Vol. 46, no. 6. — P. 210—218. — PMID 11140853.
- World Malaria Report 2008 10. World Health Organisation (2008). Дата обращения: 17 августа 2009.
- Biodiversity of the Malaria in the World, Sylvie Manguin et al. Editorial John Libbey, 2008. p. 23
Литература
- Gardner, M.J.; Hall, N.; Fung, E.; White, O.; Berriman, M.; Hyman, R.W.; Carlton, J.M.; Pain, A.; Nelson, K.E.; Bowman, S.; Others,. Genome sequence of the human malaria parasite Plasmodium falciparum (англ.) // Nature. — 2002. — Vol. 419, no. 6906. — P. 498—511. — doi:10.1038/nature01097. — . — PMID 12368864.
- Allison A.C. Protection Afforded by Sickle-cell Trait Against Subtertian Malarial Infection (англ.) // Br Med J : journal. — 1954. — February (vol. 1, no. 4857). — P. 290—294. — doi:10.1136/bmj.1.4857.290. — PMID 13115700.
- Mockenhaupt F.P., Ehrhardt S., Otchwemah R., et al. Limited influence of haemoglobin variants on Plasmodium falciparum msp1 and msp2 alleles in symptomatic malaria (англ.) // Trans. R. Soc. Trop. Med. Hyg. : journal. — 2004. — May (vol. 98, no. 5). — P. 302—310. — doi:10.1016/j.trstmh.2003.10.001. — PMID 15109555.